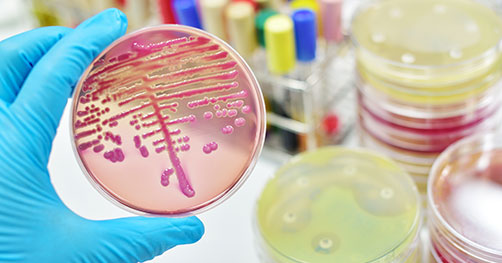

og-microbiology-lab-i-499775068-502x263.jpg
Size of this preview: 502 × 263 pixels. Other resolutions: 50 × 26 pixels 125 × 65 pixels 251 × 131 pixels 376 × 197 pixels 502 × 263 pixels
og-microbiology-lab-i-499775068-502x263.jpg ( 502 × 263 pixels )
Information
| Date: | 2025/02/08 04:34 |
|---|---|
| Filename: | og-microbiology-lab-i-499775068-502x263.jpg |
| Format: | JPEG |
| Size: | 36KB |
| Width: | 502 |
| Height: | 263 |